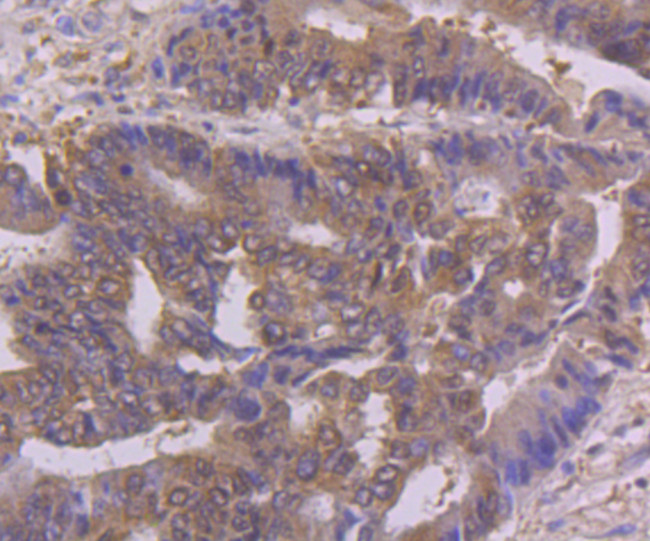
NFIB Antibody in Immunohistochemistry (Paraffin) (IHC (P))

Search
Invitrogen
NFIB Monoclonal Antibody (1H1)
{{$productOrderCtrl.translations['antibody.pdp.commerceCard.promotion.promotions']}}
{{$productOrderCtrl.translations['antibody.pdp.commerceCard.promotion.viewpromo']}}
{{$productOrderCtrl.translations['antibody.pdp.commerceCard.promotion.promocode']}}: {{promo.promoCode}} {{promo.promoTitle}} {{promo.promoDescription}}. {{$productOrderCtrl.translations['antibody.pdp.commerceCard.promotion.learnmore']}}






Please note: We are reviewing Western blot images included in the antibody testing data in our catalog, including those provided by third parties. Unless expressly labeled or annotated as “raw-unedited”, Western blot images included in the antibody testing data in our catalog may have been edited, optimized or otherwise adjusted for presentation.
产品信息
MA5-45062
种属反应
宿主/亚型
分类
类型
克隆号
抗原
偶联物
形式
浓度
规格
纯化类型
保存液
内含物
保存条件
运输条件
RRID
靶标信息
NF-1, also designated CTF, consists of a family of CCAAT box binding proteins that stimulate DNA replication and activate transcription. Analysis of human NF-1 messenger RNA has revealed two forms of the NF-1 protein arising from an alternate splicing of a single NF-1 gene. NF-1 binds its consensus DNA element as a homodimer via an amino-terminal DNA binding domain, and activates transcription through a putatively novel, proline-rich, carboxy terminal transactivation domain. The NF-1 protein has been shown to recognize and bind the adenovirus type 2 promoter and activate transcription of herpes simplex virus thymidine kinase genes. The NF-1 consensus element has been found in the upstream promoter region of myriad eukaryotic genes, including that of Ha-Ras, alpha-globin, HSP 70, GRP 78, Histone H1, myelin basic protein and in the Xenopus laevis vitellogenin gene promoter.
仅用于科研。不用于诊断过程。未经明确授权不得转售。
篇参考文献 (0)
生物信息学
蛋白别名: CCAAT-box-binding transcription factor; CTF; NF-I/B; NF1-B; Nuclear factor 1 B-type; nuclear factor 1/B; Nuclear factor I/B; olfactory epithelium nuclear factor I-B; TGGCA-binding protein
基因别名: 6720429L07Rik; CTF; E030026I10Rik; NF-I/B; NF1-B; NFI-B; NFIB
UniProt ID: (Mouse) P97863
Entrez Gene ID: (Mouse) 18028, (Rat) 29227